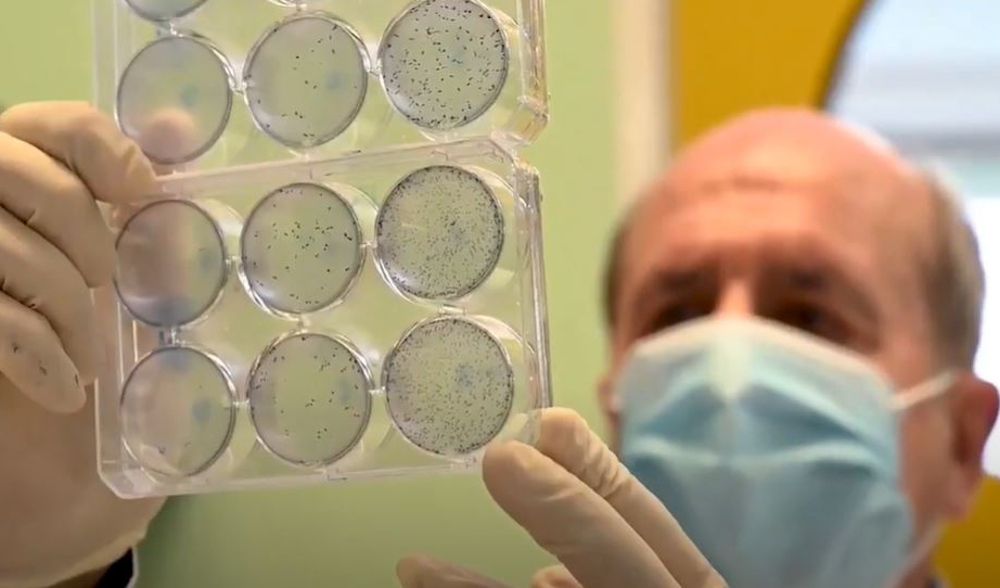

El Consejo Superior de Investigaciones Científicas (CSIC) lleva a cabo tres proyectos de vacunas contra el covid, los más avanzados de España, que podrían estar preparados para este año. Las investigaciones están al cargo de los virólogos Luis Enjuanes, Vicente Larraga y Juan García Arriaza.
El prototipo del director del Laboratorio de Coronavirus del Centro Nacional de Biotecnología del CSIC, Luis Enjuanes, utiliza ARN mensajero, pero va más allá, al basarse en un replicón ARN -creado por su equipo-, que se autoamplifica pero no se puede propagar, "lo cual lo hace muy seguro", dice el científico, quien no conoce ninguna otra en el mundo que se esté haciendo de esta manera.
Según ha explicado a la Agencia Efe, para introducir este ARN en el organismo hay que protegerlo con unas nanopartículas de lípidos, para lo que están en conversaciones con "compañías nacionales e internacionales importantes en estos temas". Su equipo tiene pensado que una multinacional europea tenga la exclusiva en la producción de la vacuna. El virólogo explica que existe una alta probabilidad de que esta ponga una fábrica en España para hacerla y quedarse en el país.
Los ensayos comenzarán pronto mediante evaluaciones en ratones humanizados, en busca de una inmunidad esterilizante ya que las actuales protegen de síntomas graves pero no del contagio.
Otra de las vacunas está en fase preclínica y está al cargo del director del laboratorio de Parasitología Molecular del Centro de Investigaciones Biológicas Margarita Salas (CIB-CSIC), Vicente Larraga. El investigador vaticina que en marzo podrían empezar con las fases clínicas I y II y en octubre o noviembre podría estar finalizada. En este caso, el equipo ya ha realizado pruebas con ratones humanizados para ver si protege frente a la infección, con un resultado "muy prometedor".
En busca de una vacuna que proteja lo más posible, el siguiente paso es determinar las vías de administración, pruebas que habrá que repetir cuando se administre a personas en los ensayos clínicos. Según ha comentado a Efe, probarán fundamentalmente con intradérmica e intramuscular.
La producción está acordada con la empresa Biofabri, y a diferencia de otras que necesitan temperaturas muy bajas, esta se conserva a temperatura ambiente y puede ser estable hasta 37 grados, lo que abre posibilidades de hacerla llegar a África, Sudamérica o el sudeste asiático.
Por último, el virólogo Juan García Arriaza trabaja con Mariano Esteban, director del grupo Poxvirus y Vacunas del Centro Nacional de Biotecnología (CNB-CSIC). Su grupo empezó hace un año a investigar un candidato a vacuna. Antes de fin de año podría estar disponible. Este modelo de vacuna produce anticuerpos "de alta calidad", y con una sola dosis "es capaz de proteger al cien por cien" de los roedores infectados.
Además, por su tipo, se suele administrar por vía intramuscular, normalmente en dos dosis, aunque también están probando la intranasal, y no haría falta cadena de frío porque se mantiene estable en temperatura ambiente. En esta caso, es la firma gallega Biofrabri la que está produciendo los lotes clínicos.
Los científicos coinciden en que hay talento, pero existe el problema de la falta de inversión en ciencia. Asimismo, han manifestado la inestabilidad laboral del personal en este ámbito.